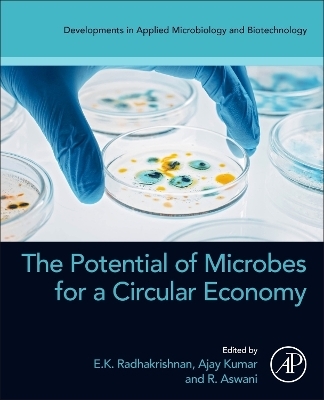
The Potential of Microbes for a Circular Economy -

The Potential of Microbes for a Circular Economy
Academic Press Inc (Verlag)
978-0-443-15924-4 (ISBN)
Dr. E.K. Radhakrishnan is currently working as an associate professor at the School of Biosciences, Mahatma Gandhi University, Kottayam and as a director at Business innovation and incubation Centre (BIIC.) During his 12 years of research, he has published 143 research publications, 43 book chapters, and 3 review papers. He has edited five books and has several books in progress. He has also been invited to deliver talks at various national and international conferences and seminars. His research areas include plant–microbe interactions, microbial natural products, microbial synthesis of metal nanoparticles, antimicrobial resistance gene prediction, and development of polymer-based nanocomposites with antimicrobial effects for food packaging and medical ap?plications. Dr. Aswani R is a postdoctoral fellow at Rajagiri College of Social Sciences, Cochin. She holds a Ph.D. in Microbiology from Mahatma Gandhi University and was awarded the Chief Minister’s NavaKerala Post-Doctoral Fellowship to conduct research at Kerala Agricultural University. Her interdisciplinary research spans biocontrol mechanisms, plant defense induction by plant-associated microorganisms, biopolymer extraction from phytomicrobiomes, nanoparticle synthesis for antimicrobial applications, and fish disease management. She has authored numerous publications, review articles, and book chapters, and is a co-editor of books including “Biocontrol mechanisms of endophytic microorganisms and “The Potential of Microbes for a Circular Economy published by Elsevier. Dr. Ajay Kumar is currently working as an assistant professor at Amity Institute of Biotechnology, Amity University, Noida, India. Dr. Kumar recently completed his tenure as a visiting scientist from Agriculture Research Organization, Volcani Center, Israel. He has published more than 175 research, review articles, and book chapters in international and national journals. He serves as an associate editor for Frontiers in Microbiology and as guest editor for various journals such as Plants, Microorganisms, and Sustainability. Dr. Kumar has also edited more than 32 books with the leading publishers such as Elsevier, Springer, and Wiley. Dr. Kumar has wide area of research experience, especially in the field of plant-microbe Interactions, microbial biocontrol, Postharvest management of fruits, microbial endophytes related to medicinal plants and cyanobacteria-pesticides interactions.
1. Introduction to circular economy-A unique approach
2. Framework for implementation of circular economy in biotechnology
3. Methods involved in the recycling and valorization of nutrients from waste biomass
4. Precision biotechnology using beneficial microbes as a fundamental approach to the circular economy
5. Development of microbial biotechnology products for phytopathogen management
6. Role of bacteria Microbial and fungi in circular agriculture economy
7. Agriculturally important functioning of beneficial microorganisms for healthy ecosystem maintenance
8. Biofertilizer and its application in sustainable bioeconomy
9. Tailored microbial inoculants in nutrient recycling and soil health maintenance
10. Development of microbial biotechnology products for sustainable agriculture
11. Microbial surfactant role in environment management and contribution in circular economy
12. Micropropagation for Crop Improvement and its commercialization potential
| Erscheinungsdatum | 13.01.2024 |
|---|---|
| Reihe/Serie | Developments in Applied Microbiology and Biotechnology |
| Verlagsort | San Diego |
| Sprache | englisch |
| Maße | 191 x 235 mm |
| Gewicht | 660 g |
| Themenwelt | Naturwissenschaften ► Biologie ► Mikrobiologie / Immunologie |
| Technik ► Umwelttechnik / Biotechnologie | |
| Wirtschaft ► Volkswirtschaftslehre | |
| ISBN-10 | 0-443-15924-6 / 0443159246 |
| ISBN-13 | 978-0-443-15924-4 / 9780443159244 |
| Zustand | Neuware |
| Informationen gemäß Produktsicherheitsverordnung (GPSR) | |
| Haben Sie eine Frage zum Produkt? |
aus dem Bereich


